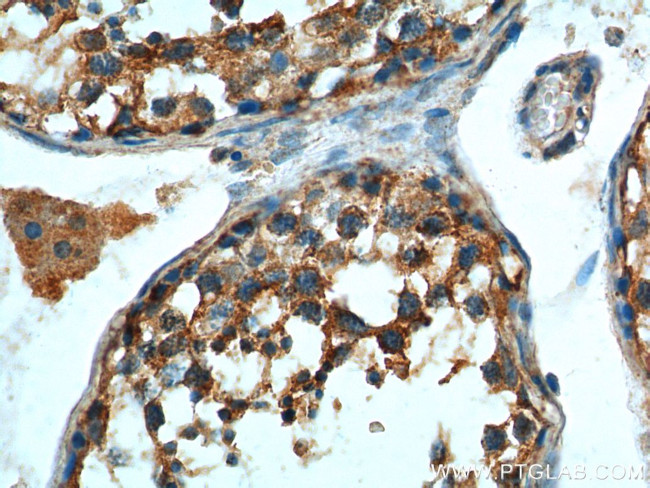
LGR6 Antibody in Immunohistochemistry (Paraffin) (IHC (P))
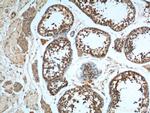
LGR6 Antibody in Immunohistochemistry (Paraffin) (IHC (P))

Search
Proteintech
LGR6 Polyclonal Antibody
{{$productOrderCtrl.translations['antibody.pdp.commerceCard.promotion.promotions']}}
{{$productOrderCtrl.translations['antibody.pdp.commerceCard.promotion.viewpromo']}}
{{$productOrderCtrl.translations['antibody.pdp.commerceCard.promotion.promocode']}}: {{promo.promoCode}} {{promo.promoTitle}} {{promo.promoDescription}}. {{$productOrderCtrl.translations['antibody.pdp.commerceCard.promotion.learnmore']}}
产品信息
17658-1-AP
种属反应
宿主/亚型
分类
类型
抗原
偶联物
形式
浓度
规格
纯化类型
保存液
内含物
保存条件
运输条件
产品详细信息
Immunogen sequence: MGRPRLTLV CQVSIIISAR DLSMNNLTEL QPGLFHHLRF LEELRLSGNH LSHIPGQAFS GLYSLKILML QNNQLGGIPA EALWELPSLQ SLRLDANLIS LVPERSFEGL SSLRHLWLDD NALTEIPVRA LNNLPALQAM TLALNRISHI PDYAFQNLTS LVVLHLHNNR IQHLGTHSFE GLHNLETLDL NYNKLQEFPV AIRTLGRLQE LGFHNNNIKA IPEKAFMGNP LLQTIHFYDN PIQFVGRSAF QYLPKLHTLS LNGAMDIQEF PDLKGTTSLE ILTLTRAGIR LLPSGMCQQL PRLRVLELSH NQIEELPSLH RCQKLEEIGL QHNRIWEIGA DTFSQLSSLQ AL (1-351 aa encoded by BC047905)
靶标信息
LGR6 has been reported to be expressed in rat adrenal, brain, colon, heart, kidney, ovary, oviduct, small intestine, spleen, testis, and uterus. ESTs have been isolated from human B-cell/lung/testis, blood, brain, colon, eye, germ cell, head/neck, heart, heart/melanocyte/uterus, lung, ovary, stomach, testis, and uterus libraries.
仅用于科研。不用于诊断过程。未经明确授权不得转售。
生物信息学
蛋白别名: FLJ14471; gonadotropin receptor; leucine-rich repeat-containing G protein-coupled receptor 6; Leucine-rich repeat-containing G-protein coupled receptor 6; LGR6; RP11-572A16.3; unnamed protein product
基因别名: A530037C04Rik; D830026M09; GPCR; LGR6; RGD1560339; UNQ6427/PRO21331; VTS20631
UniProt ID: (Human) Q9HBX8, (Mouse) Q3UVD5
Entrez Gene ID: (Human) 59352, (Mouse) 329252, (Rat) 498233